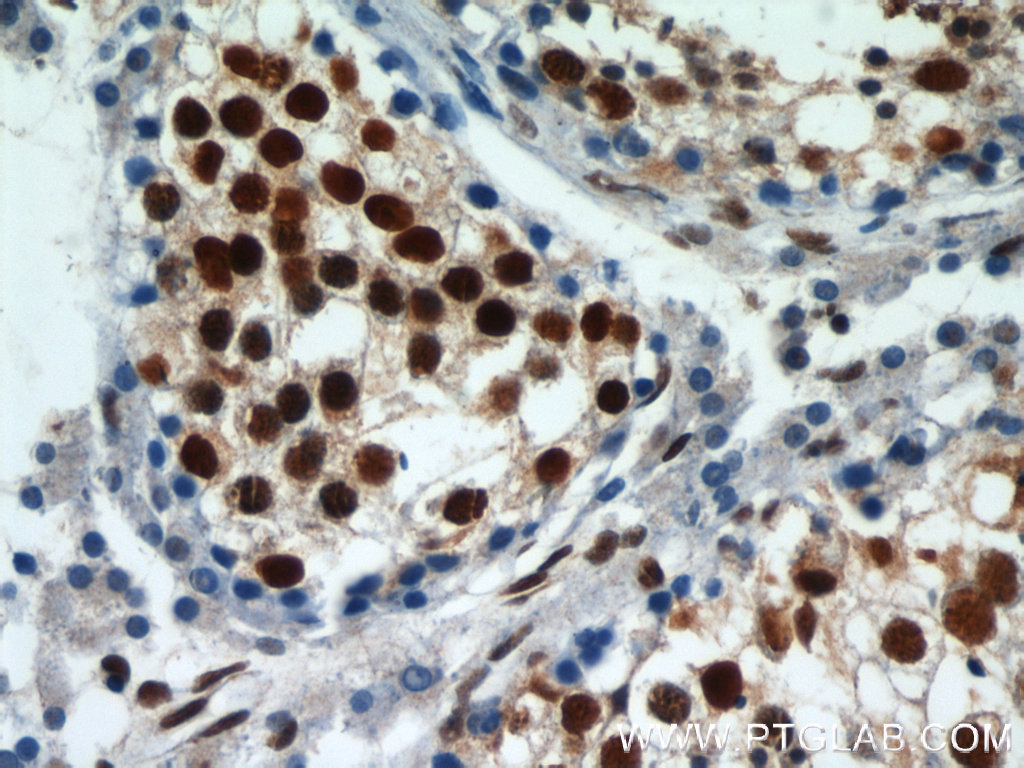

HDAC1 Antibody
KD/KO Validated
| Antibody | Catalog number | Type | Applications |
| HDAC1 | 10197-1-AP | Rabbit Poly | ELISA, FC, IF, IHC, IP, WB |
Histone deacetylases (HDACs) are a class of enzymes that remove the acetyl groups from the lysine residues in histones. This modification condenses and transcriptionally silences regions of chromatin. Due to their influence on gene expression, HDACs play a crucial role in development and physiology, having many implications for disease and therapy.
As an example, placental multidrug resistanceassociated protein 2 (MRP2), an HDAC, plays a significant role in regulating drugs' transplacental transfer rates. While working with Proteintech HDAC1 antibody (10197-1-AP), Duan and colleagues showed that HDACs inhibition can up-regulate placental MRP2 expression.1
![]() |
| Immunohistochemical staining of paraffin-embedded human testis using HDAC1 antibody (10197-1-AP) at a dilution of 1:50 (under 40x lens). |
![]() |
| 1X10^6 HeLa cells were stained with the 0.2ug HDAC1 antibody (10197-1-AP, red) and a control antibody (blue). Fixed with 90% MeOH blocked with 3% BSA (30 min). Alexa Fluor 488-conjugated AffiniPure Goat Anti-Rabbit IgG (H+L) at a dilution of 1:1000. |
Related Products
| Antibody | Catalog number | Type | Applications |
| HDAC1 | 66085-1-Ig | Mouse Mono | ELISA, IF, IHC, WB |
| HDAC2 - KD/KO Validated | 12922-3-AP | Rabbit Poly | ELISA, FC, IF, IHC, IP, WB |
| HDAC3 - KD/KO Validated | 10255-1-AP | Rabbit Poly | ELISA, IHC, IP, WB |
| HDAC4 -KD/KO Validated | 17449-1-AP | Rabbit Poly | ELISA, chIP, IF, IHC, IP, WB |
| HDAC4-Specific | 16165-1-AP | Rabbit Poly | ELISA, WB, IP, IHC |
| HDAC5-Specific | 16166-1-AP | Rabbit Poly | ELISA, WB, IHC, IF |
| HDAC6 | 12834-1-AP | Rabbit Poly | ELISA, IF, IHC, IP, WB |
| HDAC7 | 26207-1-AP | Rabbit Poly | ELISA, IP |
| HDAC8 | 17548-1-AP | Rabbit Poly | ELISA, WB, IP, IF |
| HDAC10 | 24913-1-AP | Rabbit Poly | ELISA, WB, IHC, IF |
References
1. Effect of Histone Deacetylase Inhibition on the Expression of Multidrug Resistance-associated Protein 2 in a Human Placental Trophoblast Cell Line (PMID: 28524836).